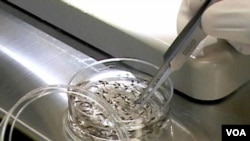
Plasmodium vivax

From VOA Learning English, this is Science in the News.
I’m Anna Matteo.
And I’m Christopher Cruise.
Today we will tell about malaria and efforts to defeat it.
Scientists say progress in medical research could reduce the number and severity of malaria cases worldwide. The World Health Organization reported recently that there has been great progress in the fight against the disease.
World Malaria Day
Many countries are organizing activities in honor of World Malaria Day this Monday, April 7th. The events will call attention to malaria and international efforts against it. The World Health Organization reports there were about 207 million cases of the disease and an estimated 627,000 malaria deaths in 2012. Most deaths were among children living in Africa. The WHO says a child there dies every minute from the disease.
Most cases of malaria are in African countries, south of one of the world’s biggest deserts -- The Sahara. Malaria also is a health threat to people living in parts of Asia, Central and South America, the Middle East, and southeastern Europe. People from malaria-free countries who visit areas with high rates of malaria are also very much at risk. This is because their bodies have little or no resistance to the disease.
The cause of malaria is a parasite called plasmodium. Mosquitoes infected with plasmodium spread the disease to human beings through mosquito bites. The parasites reproduce in the human liver, and then infect red blood cells. After they enter the blood cells, they reproduce again. As they do this, they destroy the cells.
Signs of the disease appear in victims 10 to 15 days after they are bitten. People with malaria develop a high body temperature. They also can become weak, violently expel material from the stomach, and suffer pain in the head or muscles. If not treated, malaria can make the victim sick and even cause death.
A parasite called plasmodium falciparum is responsible for most malaria infections. But experts say a lesser-known form of the disease could become a more serious threat in the future. They are seeing an increase in infections from the plasmodium vivax parasite.
An estimated 2.5 billion people live in areas where plasmodium vivax is common. Until recently, experts believed 95 percent of the at-risk population in some areas was protected from vivax infection. This was because they lack a protein in their red blood cells called a “Duffy” protein. Without it, vivax parasites cannot enter the blood cells. But researchers have found that in Madagascar, people without the Duffy protein may be carrying the vivax parasite. They say it appears the parasite may be changing so it can fight off natural resistance and infect blood cells that lack the Duffy protein.
Worldwide Fight Against Malaria Appears to Be Succeeding
Researchers remain concerned about the rising number of vivax malaria cases. But the worldwide effort against malaria appears to be succeeding. The World Health Organization recently reported that millions of lives have been saved since 2000 with better prevention and better medicines. And health officials expect even more success as governments and private groups target African countries like Kenya.
The WHO’s latest report on malaria says three million people -- most of them children -- have been saved. And it says the death rate has been cut almost in half.
Dr. Robert Newman heads the organization’s global malaria program.
“There’s been a large increase over the last 12 years in financing for malaria control efforts, and that has purchased life-saving commodities like long-lasting insecticide-treated bed nets, insecticides for indoor spraying, diagnostic tests -- especially rapid diagnostic tests -- and anti-malarial medicines.”
Malaria is a serious problem in more than 100 countries. Dr. Newman expects the number of deaths from malaria to drop even more over the next 10 years.
“I do think that we are going to see an incredible decade of success ahead, especially as people realize that this is a proven public health investment, that there's a tremendous return on the investments that are made year to date, and that we have millions more lives that can be saved over the next 10 years.”
He predicts a vaccine will be ready within 20 years that will reduce the number of cases by 75 percent.
Experts say without malaria, productivity will increase. People will be better able to provide food for their families. And they can spend the money they would use on anti-malarial drugs on other things. Countries can give increased attention to other health needs.
Dr. Joy Phumaphi works with the African Leaders Malaria Alliance.
“Once you don’t have children’s wards in hospitals dominated by malaria, by children suffering from malaria, like you currently have in a lot of these endemic countries, you are going to free up a lot of resources that are going to combat the other diseases that are challenging our communities.”
Controlling Malaria
Issues in the fight against malaria include a growing resistance to anti-malarial drugs and insecticide products. But Dr. Newman says there is an even bigger threat.
“The most serious threat to malaria control and ultimate elimination is actually a financial one.”
The main effort to control malaria involves treatment of bed nets and indoor living areas with insecticides -- products used to kill insects. The WHO says insecticide use has greatly reduced the number of malaria cases. It says insecticide-treated bed nets have been shown to reduce the number of malaria cases by 50 percent and the infection rate by 90 percent.
“Here’s a tale without an ending, about a princess that needs defending…”
Recently, the Against Malaria Foundation worked with a group of students to create a short video about the dangers of malaria. Film star Susan Sarandon became interested in their work. She volunteered to serve as the announcer for the video project.
“The evil King Malaria fed. His parasites then began to spread. Through the cells and to the liver. Her blood becomes a deadly river.”
In the video, a little girl is seen falling asleep. You would think she might have a peaceful dream of a child. But instead, a large mosquito attacks the girl, and she becomes infected with malaria.
“This nightmare is a worldwide threat, yet the simplest thing can stop it - a net. It’s such a small thing to buy; so, millions like the princess will not die.”
That was actress Susan Sarandon in “Nightmare,” a short animated video warning about the dangers of malaria.
The UN Children’s Fund and other organizations supply bed nets to affected areas. Agencies that offer help to prevent and treat malaria say they have only half the money they need. Without financial help, the groups warn, gains will be stopped.
Early identification and drug treatment can reduce the severity of malaria and prevent death. The anti-malarial drug chloroquine was widely used until recent years when the malaria parasite became resistance to the drug. Now, the WHO advises use of artemisinin-based combination treatments, or ACTs, for malaria patients.
The WHO says the international community is now in a position to defeat malaria. It says that, with the use of insecticides, better testing and drug treatments, the world could reach its goal of zero malaria deaths by 2015. Still, it says, there is an immediate need for the international community to continue and increase its investment in the fight against malaria.
Laser-Beam Scanner Tests for Malaria
Researchers have developed what they are calling the first non-invasive method of identifying a malaria infection in the human body. They are now using a laser beam scanner to test for the disease without opening up the body. The test is painless, does not require blood from a person, and appears to be right every time it is done.
Currently, medical workers study a blood sample under a microscope for evidence of the deadly parasite. The test requires a trained technician, costly equipment and time -- things that are not always available in poorer countries.
The new device only requires a person to place a finger on a laser device. Dr. Dmitri Lopotko is a researcher at Rice University in Houston, Texas.
“We shine a very short light pulse through the skin. And this light pulse is absorbed only by malaria parasites because of the wavelength we use. And in response to this short light pulse, the parasite literally explodes.”
The light comes from a low-powered laser. The device has less power than a laser pointer. It shines on a very small particle called hemozoin. The malaria parasite produces the particle after it has infected red blood cells. Hemozoin crystals are not found in normal red blood cells.
As the laser heats the crystals, they create small bubbles inside infected cells. Dr. Lopotko says the bubbles explode, and then make a sound that scientists can hear and count.
“You can detect just (a) few infected cells by a million normal cells.”
Dr. Lopotko says when researchers tested the device it was never wrong, and it was able to find malaria infection early, when treatment is very important.
The device can be carried, and depends on battery power. It costs about $10,000 to $20,000 to manufacture. But Dr. Lopotko says that is not a lot of money if one considers the number of people it can test.
“Each device will be capable to screen more than 200,000 people per year. So the cost of analysis for each patient will be less than 50 cents.”
People without medical training can use the device to discover whether people are infected with malaria.
Dr. Lopotko says the light beam has shown to be safe in volunteers. Researchers will now test the device at a Houston hospital that cares for patients infected with malaria. If those tests are successful, researchers will test the device throughout the world this year.
A report describing the malaria detection device was published in the journal Proceedings of the National Academy of Sciences.
This Science in the News was written and produced by Christopher Cruise, from reports by Carol Pearson and Jessica Berman in Washington.
I’m Anna Matteo.
And I’m Christopher Cruise.
Join us again next week for more news about science on the Voice of America.
We are sorry, but this feature is currently not available